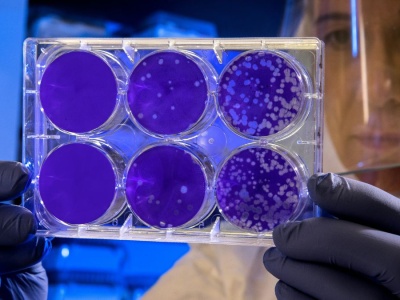
NASA odkryła bakterię, która potrafi udawać martwą. Znamy jej sekret

Nowe badania opublikowane w Microbiology Spectrum ujawniły, że tajemnicza bakteria Tersicoccus phoenicis potrafi udawać martwą tak perfekcyjnie, że przez lata oszukiwała systemy NASA. Ukrywała się w najczystszych pomieszczeniach na Ziemi, przetrwała sterylizację UV i chemikalia. Teraz wiemy, jak to...
źródło: https://holistic.news/nasa-tajemnicza-bakteria-przetrwanie/
dodano: 2025-11-17 13:59:10
Inne znaleziska:
Ziemia była świeżo przekopana. Prawda, którą odkryła policja, aż mrozi
Ziemia była świeżo przekopana. Prawda, którą odkryła policja, aż mrozi
Na spokojnej z pozoru posesji w gminie Nowa Słupia pod Ostrowcem Świętokrzyskim wydarzyło się coś, co trudno pojąć. W słoneczną lipcową sobotę jedna z mieszkanek zauważyła niepokojące zachowanie dwóch mężczyzn. Chwilę później policjanci zjawili się n...
lelum.pl,
2025-07-20 13:46:05
2025-07-20 13:46:05
Emerytowany nauczyciel: Uczeń nie potrafi napisać żadnego pisma, nie potrafi udzielić odpowiedzi ust...
Emerytowany nauczyciel: Uczeń nie potrafi napisać żadnego pisma, nie potrafi udzielić odpowiedzi ustnej
Wielokrotnie poruszaliśmy temat braków w wyposażeniu szkół. Zgłaszali się do nas nauczyciele, którzy przyznawali, że w wielu placówkach na podstawowe rzeczy po prostu nie ma pieniędzy. Papier do drukarki, mazaki do tablicy, ozdoby klasowe - wszystko...
edziecko.pl,
2025-10-30 13:50:15
2025-10-30 13:50:15
Zagadka matematyczna, która potrafi zmylić. Pomyśl, zanim odpowiesz
Zagadka matematyczna, która potrafi zmylić. Pomyśl, zanim odpowiesz
Gotowy na nowe wyzwanie? Tym razem czeka na ciebie zagadka matematyczna, która wymaga nie tylko znajomości podstawowych zasad matematyki, ale też uwagi, skupienia i spostrzegawczości.
hub.pl,
2025-10-29 15:37:25
2025-10-29 15:37:25
NASA: wielkie odkrycie na Marsie. Łazik Perseverance odnalazł próbkę, która zmieni naukę
NASA: wielkie odkrycie na Marsie. Łazik Perseverance odnalazł próbkę, która zmieni naukę
Czerwona Planeta znów zaskakuje. Po latach mozolnych badań i setkach przejechanych metrów, łazik Perseverance natrafił na coś, co każe nam na nowo przemyśleć historię Marsa. To odkrycie, które może okazać się najważniejszym w całej dotychczasowej eks...
chip.pl,
2025-09-11 09:18:11
2025-09-11 09:18:11
Dziesiątki tysięcy trzęsień. Odkryła je sztuczna inteligencja
Dziesiątki tysięcy trzęsień. Odkryła je sztuczna inteligencja
Naukowcy wykorzystali sztuczną inteligencję do zidentyfikowania ponad 86 tys. trzęsień ziemi w kalderze Yellowstone od 2008 do 2022 r. To 10-krotnie więcej niż wcześniej rejestrowano tradycyjnymi metodami.
tech.wp.pl,
2025-07-23 11:12:05
2025-07-23 11:12:05
Anna Mucha na tropie afery! Niebywałe, co odkryła w hotelu
Anna Mucha na tropie afery! Niebywałe, co odkryła w hotelu
Anna Mucha postanowiła podzielić się z internautami pewną historią. Aktorka wyjawiła, dlaczego hotelowe sejfy często nie są żadnym zabezpieczeniem dla gości.
plotek.pl,
2025-08-31 15:15:08
2025-08-31 15:15:08
Von der Leyen odkryła karty w sprawie Ukrainy. Niemiecki minister: To niewłaściwe
Von der Leyen odkryła karty w sprawie Ukrainy. Niemiecki minister: To niewłaściwe
Szef resortu obrony Niemiec Boris Pistorius krytykuje fakt, że przewodnicząca Komisji Europejskiej Ursula von der Leyen publicznie omawia opcje militarne dla Ukrainy. Wskazuje przy tym na granice, jakie stawia UE. Minister obrony Niemiec Boris Pisto...
innpoland.pl,
2025-09-01 18:56:15
2025-09-01 18:56:15
Wisła odkryła kolejną tajemnicę. Jest zbita "starymi, kutymi gwoździami". Może mieć 400 lat
Wisła odkryła kolejną tajemnicę. Jest zbita "starymi, kutymi gwoździami". Może mieć 400 lat
Utrzymujący się niski poziom wody na Wiśle odsłonił intrygującą drewnianą konstrukcję. Jej znalazca od razu stwierdził, że to coś nietypowego. Odkryciu przyjrzał się następnie archeolog, który potwierdził, że mamy prawdopodobnie do czynienia z drewni...
g.pl,
2025-09-05 11:44:15
2025-09-05 11:44:15
Para stosowała przemoc wobec dziecka. Podczas kontroli policja odkryła narkotyki
Para stosowała przemoc wobec dziecka. Podczas kontroli policja odkryła narkotyki
W dniu 11 września 2025 r., do Komisariatu Policji w Trzemesznie zgłosiła się mieszkanka Mogilna, informując o podejrzeniu stosowania przemocy przez matkę i jej konkubenta wobec 3-letniego dziecka. Przemoc miała miejsce zarówno w Mogilnie, jak i w je...
fakt.pl,
2025-09-15 23:15:21
2025-09-15 23:15:21
Jennifer Aniston przyjaźni się z Reese Witherspoon od lat. Dopiero teraz odkryła jej prawdziwe imię
Jennifer Aniston przyjaźni się z Reese Witherspoon od lat. Dopiero teraz odkryła jej prawdziwe imię
W ostatnim czasie Jennifer Aniston miała okazję poznać prawdziwe imię swojej długoletniej przyjaciółki, Reese Witherspoon. Aktorki, które łączą wieloletnie więzi zarówno prywatne, jak i zawodowe, wzięły udział w zabawnej grze, k...
naekranie.pl,
2025-09-21 14:43:16
2025-09-21 14:43:16